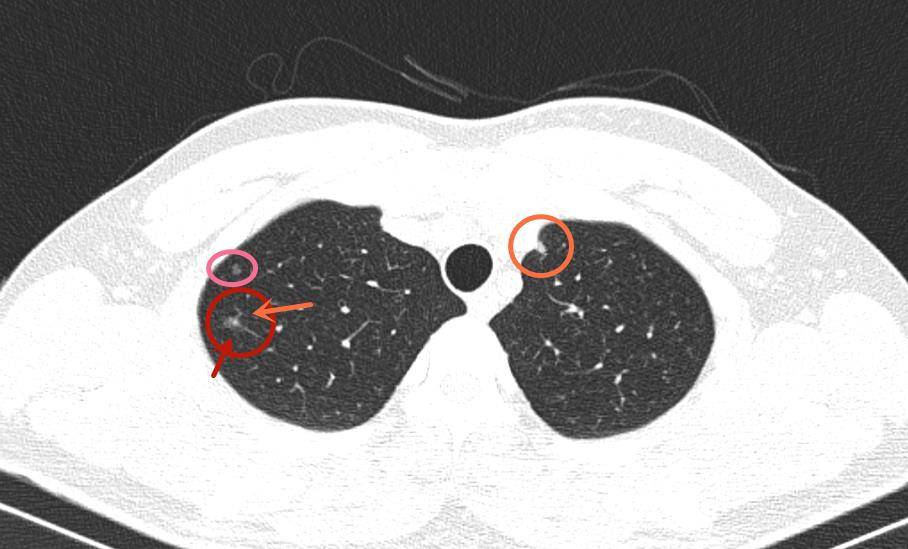
密度不均,中间有高密度;邻近区域有个小的伴小空泡的微小磨玻璃结节

肺部结节高密度

肺部ct的一个圆形结节
图片尺寸512x512
影像读片双肺多发结节病例帖
图片尺寸3264x2448
混合密度结节,伴有胸膜牵拉,实性成分占50%以上,考虑中高分化腺癌,如
图片尺寸1752x1630
43岁大姐肺内查出3mm结节,一年后接近消散?她是怎么做到的?
图片尺寸627x405
结节病_结节病介绍 - 好大夫在线
图片尺寸1537x1600
肺结节磨玻璃密度结节
图片尺寸1080x810
39岁年轻患者因咳嗽于当地行肺部ct,发现右下肺混合磨玻璃密度结节
图片尺寸2976x3968
右下肺见8mmx9mm磨玻璃密度结节
图片尺寸1200x675
肺结节是肺部受损的一种表现,一般来说,肺结节较小的话,很难被察觉,不
图片尺寸640x436
肺结节读片21鉴别11mm的实性结节良恶性的技巧
图片尺寸1536x1340
混合磨玻璃密度结节一定是肺癌吗?为什么她的混磨竟然消失了?
图片尺寸2976x3968
实性结节,密度比较高,在ct影像上表现为亮度较高的高密度结节影.
图片尺寸499x310
肺部有结节不必紧张 0.5公分是临界
图片尺寸1478x1108
肺结节病例分享:左肺上叶磨玻璃结节,大约6mm
图片尺寸535x347
一个不典型的14mm磨玻璃肺结节患者百度为肺癌晚期
图片尺寸1133x2453
【讨论】30岁男性,体检发现右下肺结节影
图片尺寸1896x1400
密度不均,中间有高密度;邻近区域有个小的伴小空泡的微小磨玻璃结节
图片尺寸908x549
肺部ct发现的不规则结节和多发毛刺是什么难道是肺癌吗
图片尺寸640x496
肺腺癌是怎么长出来的?医生介绍3种肺结节,一学就会
图片尺寸640x363
右肺结节
图片尺寸3024x3024